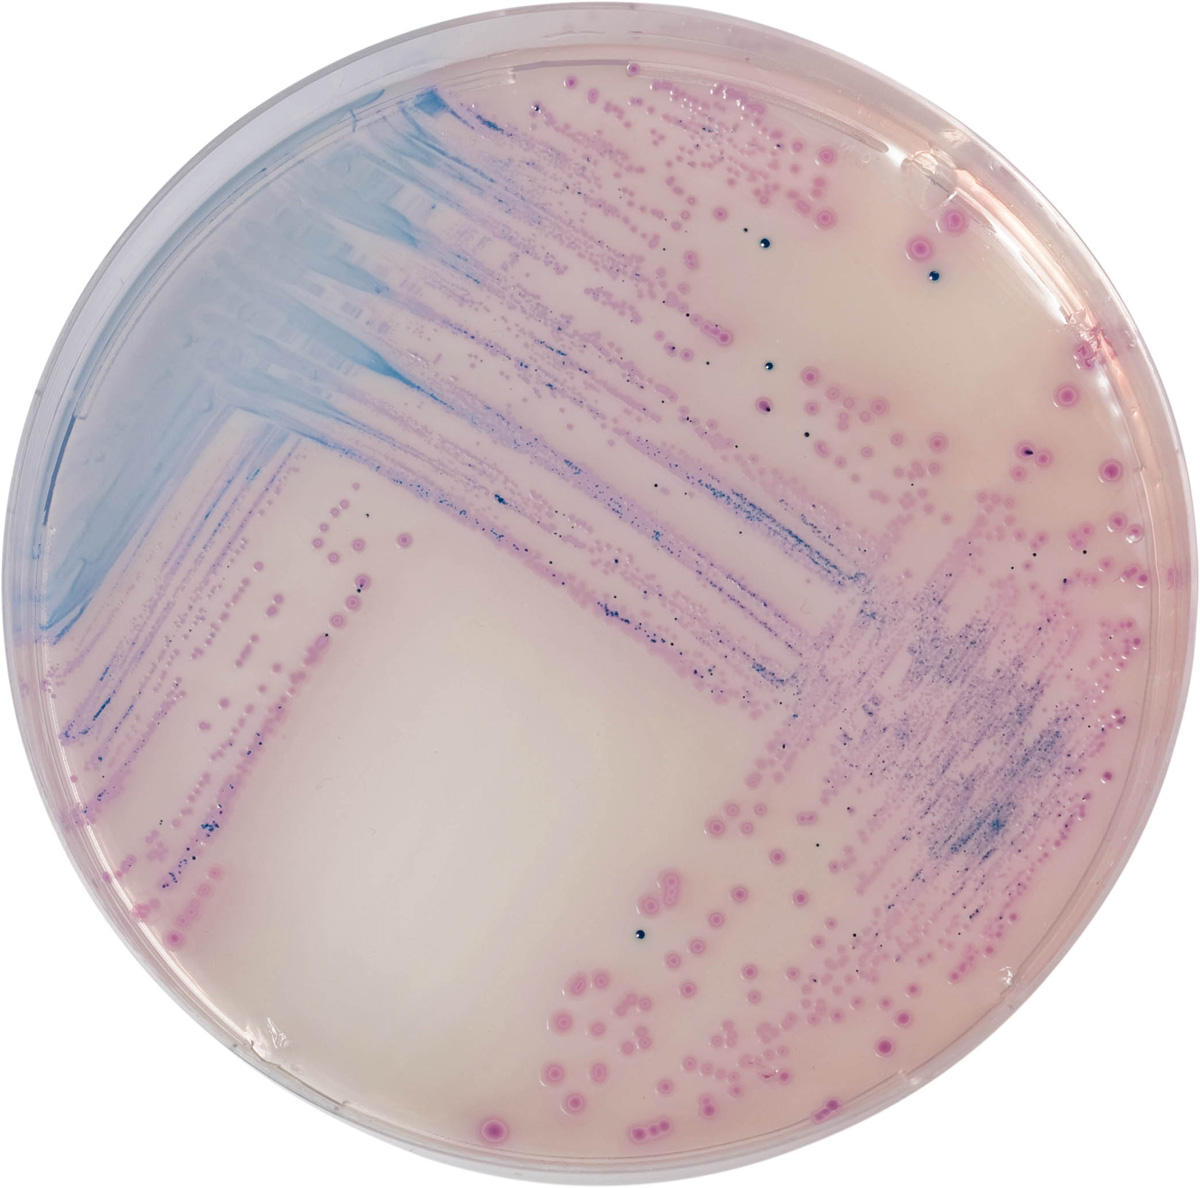

À propos du produit
CHROMagar Salmonella est utilisé pour la détection et l’isolement de Salmonella spp., y compris S.Typhi et S.paratyphi.
CHROMAGAR SALMONELLA
CHROMagar Salmonella est utilisé pour la détection et l’isolement de Salmonella spp., y compris S.Typhi et S.paratyphi.